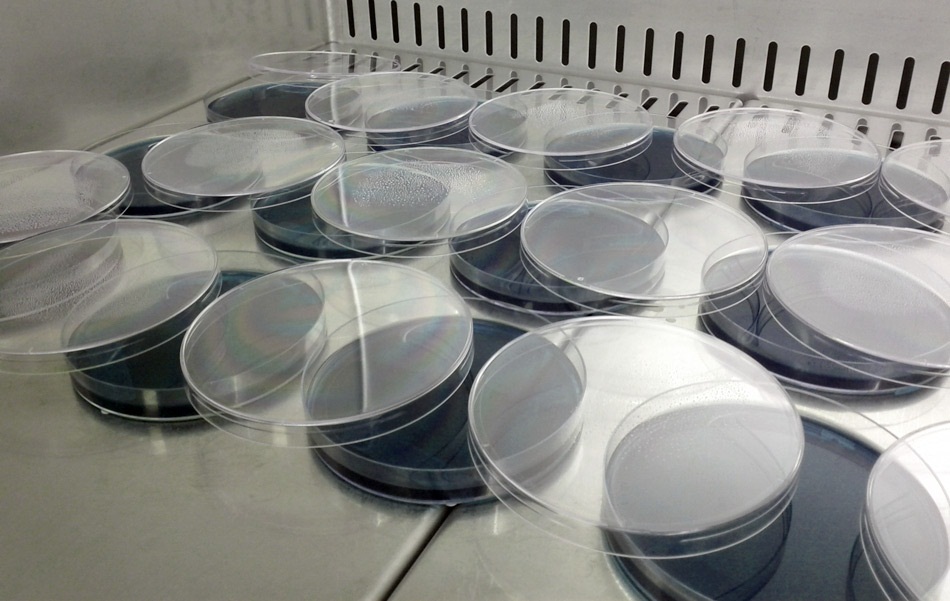
Tutto pronto per la Giornata Nazionale del Trapianto

Tutto pronto per la Giornata Nazionale del Trapianto
Domenica c’è la “Giornata Nazionale del Trapianto Donazione e Trapianto di Organi e Tessuti”, che ogni anno ricorda e promuove l’opera di sensibilizzazione sul tema della donazione degli organi. Si tratta della sedicesima edizione della manifestazione organizzata dal Ministero della Salute, insieme alle Associazioni e al Centro Nazionale Trapianti promuove, sotto l’Alto Patronato della Presidenza […]
Domenica c’è la “Giornata Nazionale del Trapianto Donazione e Trapianto di Organi e Tessuti”, che ogni anno ricorda e promuove l’opera di sensibilizzazione sul tema della donazione degli organi.
Si tratta della sedicesima edizione della manifestazione organizzata dal Ministero della Salute, insieme alle Associazioni e al Centro Nazionale Trapianti promuove, sotto l’Alto Patronato della Presidenza della Repubblica. Un’occasione per avvicinarsi al mondo della donazione degli organi con coscienza e consapevolezza e diffondere il messaggio di cui si fa promotore anche l’Agenzia Regionale del Lazio per i Trapianti e le Patologie connesse che lavora su questo dal 2006. Per l’occasione il commissario straordinario dell’ente ha realizzato un video messaggio disponibile sul sito internet: www.agenziatrapiantilazio.it

